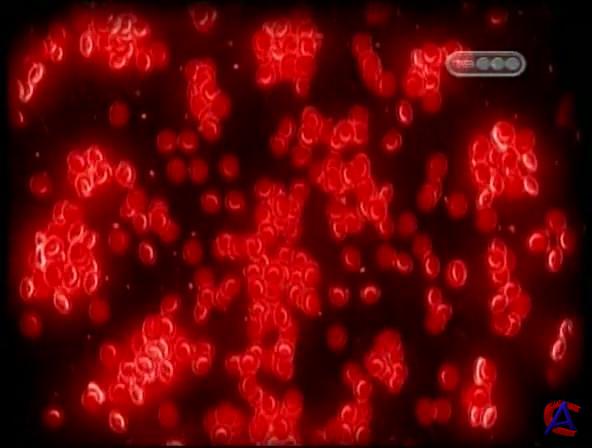

|
|
|
||||||||||||||||||||||||||||||||||||||||||||||||||||||||||||||||||||||||||||||||||
|
|
|
|
|
Программирование: "UserSide", "Atlant_is" Дизайн: Atlant_is и "UserSide" |
Система "Magneto" v.2.0.1 ©2008-2010 - http://www.userside.org.ua/magneto/ |
Magnetida v.1.02b - 07.01.2012 Автор модуля: Atlant_is Страница генерировалась: 0.2 с. |





 HISTORY - Жизнь после людей / Life After People
HISTORY - Жизнь после людей / Life After People ХРОНИКИ КОПАРЯ: ОТ ВОЙНЫ К СТАРИНЕ
ХРОНИКИ КОПАРЯ: ОТ ВОЙНЫ К СТАРИНЕ Метро Новосибирска
Метро Новосибирска Я – Брюс Ли / I Am Bruce Lee
Я – Брюс Ли / I Am Bruce Lee Подсекай, Семёныч (фильм 6) Ловля карпа от любителя до профессионала.
Подсекай, Семёныч (фильм 6) Ловля карпа от любителя до профессионала.